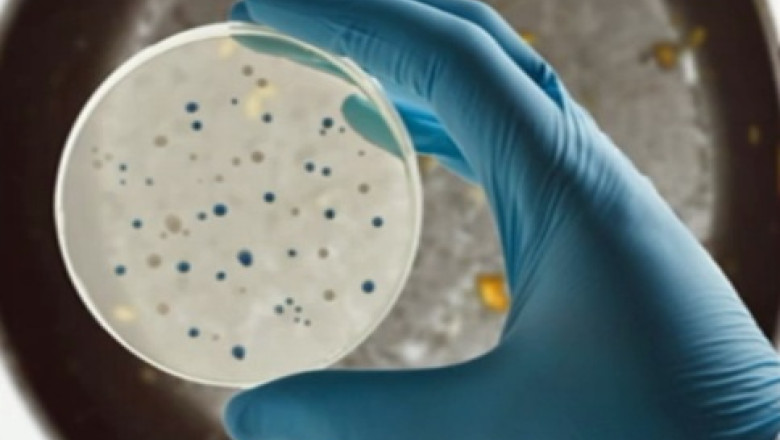
Microbii din casa. Cat de des trebuie schimbate tigaile, pernele, cosmeticele Imagine

Începem cu bucătăria. Tigaia dumneavostră este din teflon şi e foarte zgâriată? Mai bine cumpăraţi una nouă. Atunci când gătiţi, bucăţi de teflon se desprind şi ajung în mâncare. Învelişul tigăii antiaderente este format dintr-o substanţă care poate creşte riscul de cancer.
10 milioane de microbi se pot ascunde în doar 2,5 cm pătraţi ai unui burete!
Acum că aveţi o tigaie nouă, nu va grăbiţi să o spălaţi cu un burete vechi. Cercetătorii americani susţin că un burete poate fi de 200 de mii de ori mai murdar decât vasul de toaletă! De aceea, schimbaţi-l măcar o dată la trei săptămâni, în funcţie de cât de mult îl folosiţi.
Tot la trei săptămâni ar trebui schimbat şi buretele sau lufa de baie, care conţine o mulţime de celule moarte, hrană ideală pentru microorganisme.
Adevăratul pericol pentru sănătate stă însă în periuţa de dinţi!
Gândiţi-vă că atunci când trageţi apa, multe din bacterii trec în aer, iar din aer pe… periuţă. De aceea, este recomandat să o schimbaţi o dată la trei luni sau chiar mai des. Studiile spun însă că un român păstreză aceeaşi periuţă timp de aproximativ un an şi jumătate!
Trecem la pernă. Atunci când este veche, o treime din greutatea ei poate fi formată din piele moartă, bacterii şi chiar gâze. Cele mai periculoase sunt pernele din spitale, care conţin o mulţime de stafilococi. Însă şi în cele de acasă pot fi găsite uneori bacterii care pot determina infecţii respiratorii. Aşa că spălaţi-o la temperaturi înalte cât de des puteţi şi schimbaţi-o o dată la doi-trei ani.
Cuiburi pentru microbi pot fi şi fardurile sau pensulele de machiaj pe care le folosiţi zilnic. În special femeile care îşi ţin rimelul sau fardul de ochi în baie ar trebui să le schimbe mai des. Pensulele intră în contact cu sebumul pielii, o hrană excelentă pentru dezvoltarea bacteriilor. Statisticile arată că româncele folosesc chiar şi câţiva ani un fard de pleoape. Astfel pot face blefarite sau conjunctivite.
fard de pleoape - între 18 şi 24 de luni;
gloss/ ruj - între 18 şi 24 de luni;
rimel - 6 luni
În plus, multe probleme ale pielii sunt puse pe seama fondului de ten prea vechi sau a blush-ului de obraz. Pentru a preveni problemele în primul rând trebuie verificată data expirării cosmeticelor, dar nu numai! Există un semn distinctiv care arată câte luni poate fi folosit un produs: